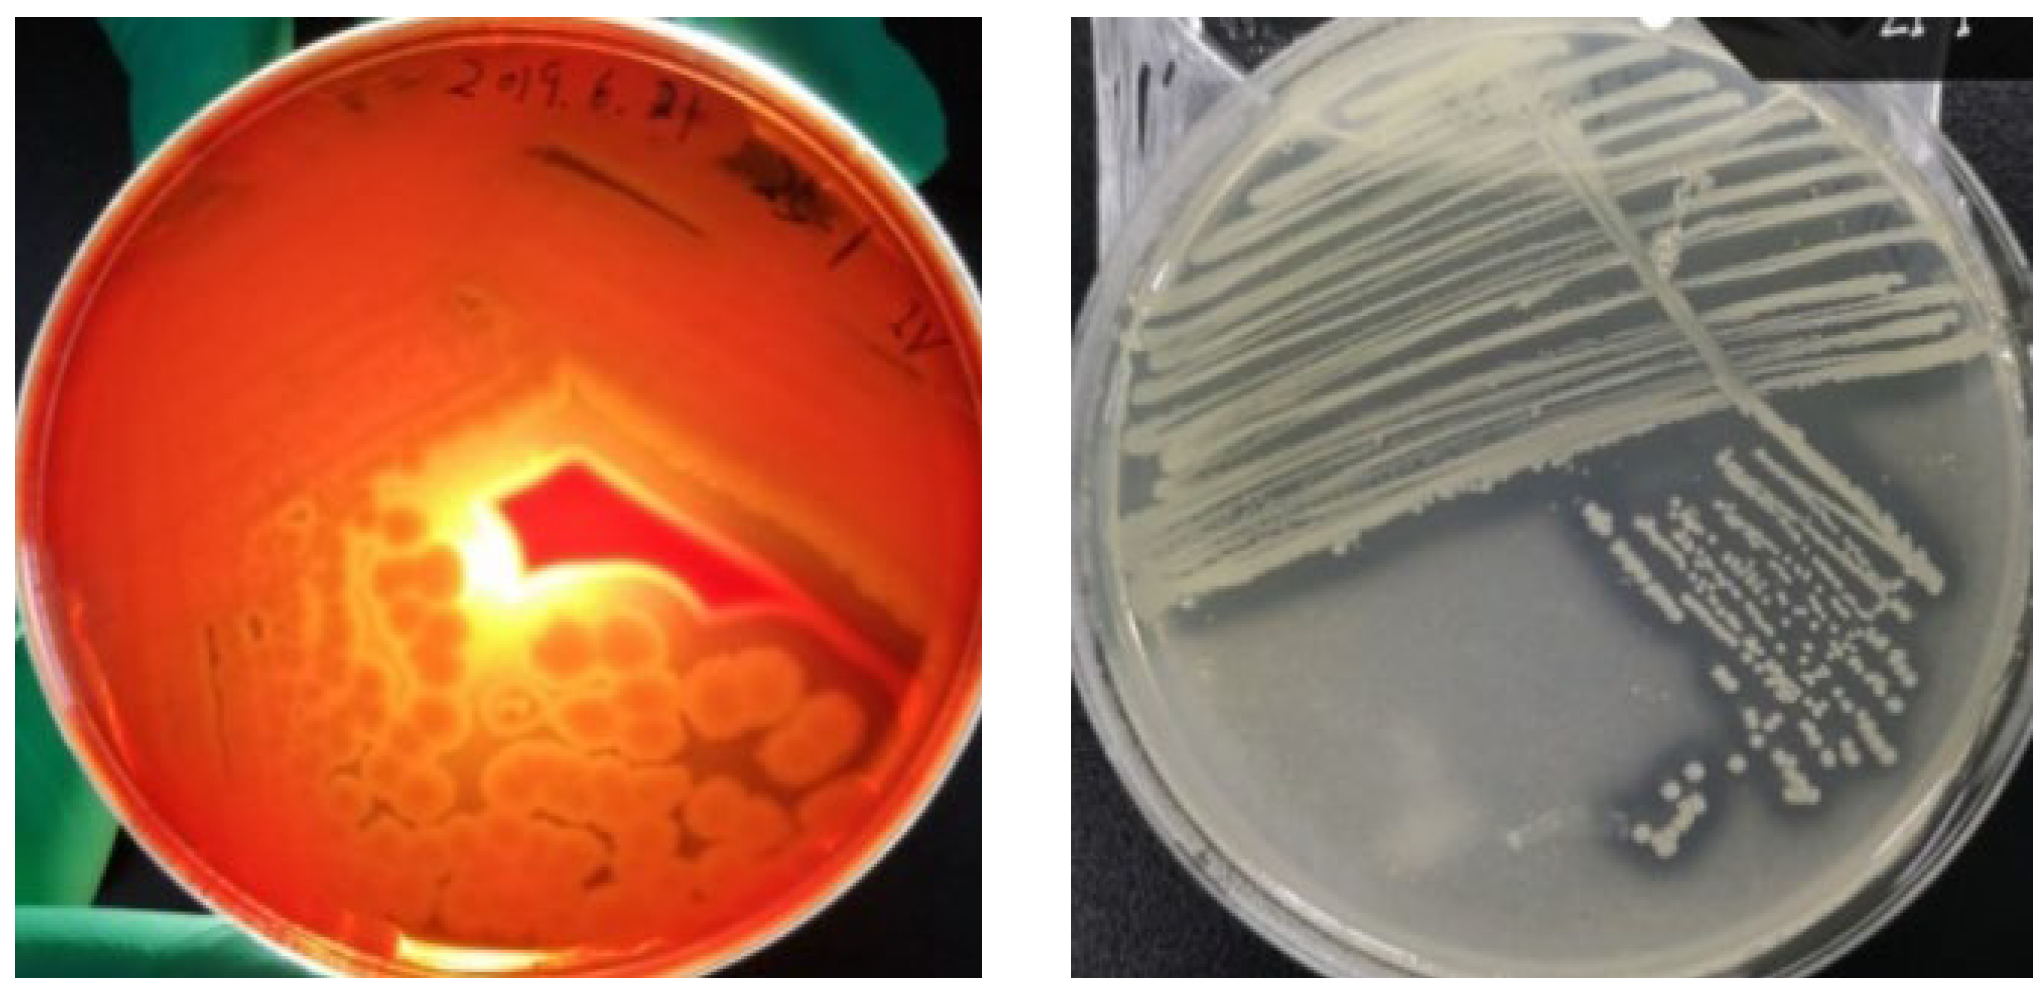
Water 16 03508 g002

Screening, Identification, and Optimization of Enzyme Production for Bacteria with High Efficiency of Bovine Blood Protein Degradation from Slaughterhouses
Abstract
1. Introduction
2. Materials and Methods
2.1. Sample Collection
2.2. Culture Media
2.3. Isolation and Purification of Strains
2.4. Strain Identification
2.5. Optimization of Protease Production Conditions
2.5.1. One-Way Tests
2.5.2. Plackett–Burman Test
2.5.3. Response Surface Methodology Tests
3. Results and Discussion
3.1. Isolation and Screening of Strains
3.2. Strain Identification
3.3. Optimization of Enzyme Production Conditions
3.3.1. One-Way Trial Design and Analysis
3.3.2. PB Experimental Design and Results
3.3.3. Response Surface Test Design and Results
3.4. Comparison with Previous Studies and Future Research Directions
4. Conclusions
Author Contributions
Funding
Data Availability Statement
Conflicts of Interest
References
- Bah, C.S.F.; Bekhit, A.E.A.; Carne, A.; McConnell, M.A. Slaughterhouse Blood: An Emerging Source of Bioactive Compounds. Compr. Rev. Food Sci. Food Saf. 2013, 12, 314–331. [Google Scholar] [CrossRef]
- Rezapoor, P.; Rahimpour, M.R. Animal Waste to Energy, Technologies, Economics, and Challenges. In Animal Waste to Energy, Technologies, Economics, and Challenges; Elsevier: Amsterdam, The Netherlands, 2024; pp. 61–70. [Google Scholar] [CrossRef]
- Tong, S.; Zhao, Y.; Zhu, M.; Li, J.; Liu, S.; Chen, S. Current status and research progress of slaughtering and meat processing wastewater treatment. Ind. Water Treat. 2019, 39, 6–10. [Google Scholar]
- Jiang, D. Experimental Study on Alkaline Modification and Methane-Methanol Bioconversion of Straw-Based Biomass for Anaerobic Fermentation. Doctoral Thesis, Henan Agricultural University, Zhengzhou, China, 2018. [Google Scholar]
- Li, J.; Otero-Gonzalez, L.; Michiels, J.; Lens, P.N.L.; Laing, G.D.; Ferrer, I. Production of selenium-enriched microalgae as potential feed supplement in high-rate algae ponds treating domestic wastewater. Bioresour. Technol. 2021, 333, 125239. [Google Scholar] [CrossRef]
- Palatsi, J.; Viñas, M.; Guivernau, M.; Fernandez, B.; Flotats, X. Anaerobic digestion of slaughterhouse waste: Main process limitations and microbial community interactions. Bioresour. Technol. 2011, 102, 2219–2227. [Google Scholar] [CrossRef]
- Buhari, J.; Hasan, H.A.; Kurniawan, S.B.; Abdullah, S.R.S.; Othman, A.R. Future and challenges of co-biofilm treatment on ammonia and Bisphenol A removal from wastewater. J. Water Process Eng. 2023, 54, 103969. [Google Scholar] [CrossRef]
- Ramli, N.N.; Kurniawan, S.B.; Ighalo, J.O.; Said, N.S.M.; Marsidi, N.; Buhari, J.; Shah, R.A.R.; Zulkifli, M.; Alias, J.; Daud, N.M.; et al. A review of the treatment technologies for hexavalent chromium contaminated water. BioMetals 2023, 36, 1189–1219. [Google Scholar] [CrossRef]
- Alia, K.B.; Nadeem, H.; Rasul, I.; Azeem, F.; Hussain, S.; Siddique, M.H.; Muzammil, S.; Riaz, M.; Nasir, S. Separation and Purification of Amino Acids. In Applications of Ion Exchange Materials in Biomedical Industries; Springer International Publishing: Cham, Switzerland, 2019; pp. 1–11. [Google Scholar] [CrossRef]
- Hongmei, P.; Jinggang, Y.; Gang, S.; Chaomin, C.; Kai, W.; Gong, C. Study on Optimum Hydrolysis Conditions of Porcine Plasma Protein by Protease-alkaline. Sichuan Food Ferment. 2010, 46, 51–55. [Google Scholar]
- Osama, O.A.; Abdullah, S.R.S.; Hasan, H.A.; Othman, A.R.; Ewadh, H.M.; Al-Baldawi, I.A.; Sharuddin, S.S.N.; Kurniawan, S.B.; Ismail, N.I. Elimination of mixed ibuprofen and paracetamol from spiked domestic wastewater via a pilot continuous aerated sub-surface constructed wetland system. J. Water Process Eng. 2022, 50, 103308. [Google Scholar] [CrossRef]
- Imron, M.F.; Kurniawan, S.B.; Ismail, I.; Abdullah, S.R.S. Future challenges in diesel biodegradation by bacteria isolates: A review. J. Clean. Prod. 2020, 251, 119716. [Google Scholar] [CrossRef]
- MImron, F.; Kurniawan, S.B.; Abdullah, S.R.S. Resistance of bacteria isolated from leachate to heavy metals and the removal of Hg by Pseudomonas aeruginosa strain FZ-2 at different salinity levels in a batch biosorption system. Sustain. Environ. Res. 2021, 31, 14. [Google Scholar] [CrossRef]
- Titah, H.S.; Abdullah, S.R.S.; Idris, M.; Anuar, N.; Basri, H.; Mukhlisin, M.; Tangahu, B.V.; Purwanti, I.F.; Kurniawan, S.B. Arsenic Resistance and Biosorption by Isolated Rhizobacteria from the Roots of Ludwigia octovalvis. Int. J. Microbiol. 2018, 2018, 3101498. [Google Scholar] [CrossRef] [PubMed]
- Je, S.; Yamaoka, Y. Biotechnological Approaches for Biomass and Lipid Production Using Microalgae Chlorella and Its Future Perspectives. J. Microbiol. Biotechnol. 2022, 32, 1357–1372. [Google Scholar] [CrossRef] [PubMed]
- Jameel, M.K.; Mustafa, M.A.; Ahmed, H.S.; Mohammed, A.J.; Ghazy, H.; Shakir, M.N.; Lawas, A.M.; Mohammed, S.K.; Idan, A.H.; Mahmoud, Z.H.; et al. Biogas: Production, properties, applications, economic and challenges: A review. Results Chem. 2024, 7, 101549. [Google Scholar] [CrossRef]
- Mishra, M.; Shukla, S.; Mishra, A.; Zohra, F.; Singh, S.; Kushwaha, A.; Goswami, L.; Upadhyay, N. Biotechnological interventions in the valorization of the organic waste. In Bio-Based Materials and Waste for Energy Generation and Resource Management; Elsevier: Amsterdam, The Netherlands, 2023; pp. 357–385. [Google Scholar] [CrossRef]
- Ramakrishna, D.P.N.; Reddy, N.G.; Patnayak, S.; Kumar, K.S.; Rajagopal, S.V. Isolation and characterization of an alkaline protease producing Bacillus subtilis (KHS-1) from slaughterhouse soil samples. Asian J. Chem. 2010, 22, 4061–4068. [Google Scholar]
- Zbrun, M.V.; Altina, M.G.; Bonansea, E.; Frizzo, L.S.; Soto, L.P.; Romero-Scharpen, A.; Rosmini, M.R.; Sequeira, G.J.; Signorini, M.L. Identification of lactic acid bacteria with bio-preservative potential isolated from contaminated avian blood obtained at the slaughterhouse. Arch. Med. Vet. 2013, 45, 273–282. [Google Scholar] [CrossRef]
- Tao, Y.; Yao, D.; Wang, Z. Isolation, screening and identification of haemoglobin-degrading bacteria. J. Food Biotechnol. 2009, 28, 854–857. [Google Scholar]
- Zheng, Y.; Zhang, H.; Wang, D.; Gao, P.; Shan, A. Strain development and optimized fermentation conditions for blood meal using Aspergillus niger and Aspergillus oryzae. J. Microbiol. Methods. 2014, 101, 70–80. [Google Scholar] [CrossRef]
- Song, P.; Zhang, X.; Wang, S.; Xu, W.; Wang, F.; Fu, R.; Wei, F. Microbial proteases and their applications. Front. Microbiol. 2023, 14, 1236368. [Google Scholar] [CrossRef]
- Trezza, A.; Cicaloni, V.; Pettini, F.; Spiga, O. Potential roles of protease inhibitors in anticancer therapy. In Cancer-Leading Proteases; Elsevier: Amsterdam, The Netherlands, 2020; pp. 13–49. [Google Scholar] [CrossRef]
- Kocabaş, D.S.; Lyne, J.; Ustunol, Z. Hydrolytic enzymes in the dairy industry: Applications, market and future perspectives. Trends Food Sci. Technol. 2022, 119, 467–475. [Google Scholar] [CrossRef]
- Ali, S.; Khan, S.A.; Hamayun, M.; Lee, I.-J. The Recent Advances in the Utility of Microbial Lipases: A Review. Microorganisms 2023, 11, 510. [Google Scholar] [CrossRef]
- Hassan, A.; Pariatamby, A.; Ahmed, A.; Auta, H.S.; Hamid, F.S. Enhanced Bioremediation of Heavy Metal Contaminated Landfill Soil Using Filamentous Fungi Consortia: A Demonstration of Bioaugmentation Potential. Water. Air. Soil Pollut. 2019, 230, 215. [Google Scholar] [CrossRef]
- Xu, B.; Sun, Q.J.; Lan, J.C.W.; Chen, W.M.; Hsueh, C.C.; Chen, B.Y. Exploring the glyphosate-degrading characteristics of a newly isolated, highly adapted indigenous bacterial strain, Providencia rettgeri GDB 1. J. Biosci. Bioeng. 2019, 128, 80–87. [Google Scholar] [CrossRef]
- Imron, M.F.; Kurniawan, S.B.; Titah, H.S. Potential of bacteria isolated from diesel-contaminated seawater in diesel biodegradation. Environ. Technol. Innov. 2019, 14, 100368. [Google Scholar] [CrossRef]
- Zhao, R.; Wang, B.; Cai, Q.T.; Li, X.X.; Liu, M.; Hu, D.; Guo, D.B.; Wang, J.; Fan, C. Bioremediation of Hexavalent Chromium Pollution by Sporosarcina saromensis M52 Isolated from Offshore Sediments in Xiamen, China. Biomed. Environ. Sci. 2016, 29, 127–136. [Google Scholar] [CrossRef] [PubMed]
- Ngo, T.T.C.; Le, V.T.; Shinjiro, K. Identification and characterization of acidity-tolerant and aluminum-resistant bacterium isolated from tea soil. Afr. J. Biotechnol. 2014, 13, 2715–2726. [Google Scholar] [CrossRef]
- Radha, P.; Suhazsini, P.; Prabhu, K.; Jayakumar, A.; Kandasamy, R. Chicken Tallow, a Renewable Source for the Production of Biosurfactant by Yarrowia lipolytica MTCC9520, and its Application in Silver Nanoparticle Synthesis. J. Surfactants Deterg. 2020, 23, 119–135. [Google Scholar] [CrossRef]
- Purwanti, I.F.; Abdullah, S.R.S.; Hamzah, A.; Idris, M.; Basri, H.; Latif, M.T.; Mukhlisin, M.; Kurniawan, S.B.; Imron, M.F. Maximizing diesel removal from contaminated sand using Scirpus mucronatus and assessment of rhizobacteria addition effect. Heliyon 2023, 9, e21737. [Google Scholar] [CrossRef]
- Nasir, N.M.; Jusoh, A.; Manan, H.; Kasan, N.A.; Kamaruzzan, A.S.; Ghani, W.A.W.A.K.; Kurniawan, S.B.; Lananan, F. Utilization of microalgae, Chlorella sp. UMT LF2 for bioremediation of Litopenaeus vannamei culture system and harvesting using bio-flocculant, Aspergillus niger. Biocatal. Agric. Biotechnol. 2023, 47, 102596. [Google Scholar] [CrossRef]
- Xiao, G.; Chen, Y.; Fang, R.; Xiao, C.; Yuan, H.; Chu, B.; Liu, X.; Gong, J. Salt-tolerant Staphylococcus bacteria induce structural and nutritional alterations of salted duck egg white. Food Sci. Nutr. 2019, 7, 3941–3949. [Google Scholar] [CrossRef]
- Wang, L.; Zhang, B.; Han, J.; Zheng, Y.; Li, J.; Shan, A. Optimization of hydrolysis condition of blood meal by Bacillus subtilis with response surface methodology. Int. Biodeterior. Biodegrad. 2015, 104, 112–117. [Google Scholar] [CrossRef]
- Pinontoan, R.; Elvina; Sanjaya, A.; Jo, J. Fibrinolytic characteristics of Bacillus subtilis G8 isolated from natto. Biosci. Microbiota Food Heal. 2021, 40, 2020–2071. [Google Scholar] [CrossRef] [PubMed]
- Yao, K.; Liu, D.M.; Brennan, C.S. Gelatinised and hydrolysed corn starch is a cost-effective carbon source with higher production of L-lactic acid by Bacillus coagulans compared with glucose. Int. J. Food Sci. Technol. 2021, 56, 2384–2394. [Google Scholar] [CrossRef]
- Jin, B.; Huang, L.P.; Lant, P. Rhizopus arrhizus—A producer for simultaneous saccharification and fermentation of starch waste materials to L(+)-lactic acid. Biotechnol. Lett. 2003, 25, 1983–1987. [Google Scholar] [CrossRef] [PubMed]
- Mizzi, L.; Maniscalco, D.; Gaspari, S.; Chatzitzika, C.; Gatt, R.; Valdramidis, V.P. Assessing the individual microbial inhibitory capacity of different sugars against pathogens commonly found in food systems. Lett. Appl. Microbiol. 2020, 71, 251–258. [Google Scholar] [CrossRef] [PubMed]
- Kazan, D.; Çamurdan, A.; Hortaçsu, A. The effect of glucose concentration on the growth rate and some intracellular components of a recombinant E. coli culture. Process Biochem. 1995, 30, 269–273. [Google Scholar] [CrossRef]
- Li, Y.; Gan, S.; Luo, L.; Yang, W.; Mo, L.; Shang, C. Optimization of Molasses and Soybean Meal Content to Enhance Tetramethylpyrazine Yield by Bacillus sp. TTMP20. Molecules 2023, 28, 6515. [Google Scholar] [CrossRef]
- Liu, J.; Zhou, J.; Wang, L.; Ma, Z.; Zhao, G.; Ge, Z.; Zhu, H.; Qiao, J. Improving nitrogen source utilization from defatted soybean meal for nisin production by enhancing proteolytic function of Lactococcus lactis F44. Sci. Rep. 2017, 7, 6189. [Google Scholar] [CrossRef]
- Hu, M.; Wang, D.; Tang, X.; Zhang, Q.; Zhao, J.; Mao, B.; Zhang, H.; Cui, S. Improving the utilization efficiency of nitrogen source through co-culture of Lactobacillus strains with different nitrogen source metabolisms. LWT 2024, 191, 115701. [Google Scholar] [CrossRef]
- Chai, J.M.; Adnan, A. Effect of different nitrogen source combinations on microbial cellulose production by Pseudomonas aeruginosa in batch fermentation. IOP Conf. Ser. Mater. Sci. Eng. 2018, 440, 012044. [Google Scholar] [CrossRef]
- Tambekar, S.D.; Tambekar, D.H. Optimization of the production and partial charaterization of an extracellular alkaline protease from thermo-halo-alkalophilic Lonar lake bacteria. Biosci. Discov. 2013, 4, 30–38. Available online: http://biosciencediscovery.com (accessed on 1 October 2024).
- Kang, S.-M.; Titus, J.S. Effect of phosphate on protease activity of senescing rice leaves. Phytochemistry 1992, 31, 401–404. [Google Scholar] [CrossRef]
- Douterelo, I.; Dutilh, B.E.; Calero, C.; Rosales, E.; Martin, K.; Husband, S. Impact of phosphate dosing on the microbial ecology of drinking water distribution systems: Fieldwork studies in chlorinated networks. Water Res. 2020, 187, 116416. [Google Scholar] [CrossRef] [PubMed]
- Xiao-yan, L.; Jian, F.; Ao, H.; Ning, G.; Lian, L.; Li-dong, G.C.; College of Pharmacy, Heilongjiang University of Chinese Medicine. Medicine, Isolation and Optimization of Bacillus subtilis W1 Strain with High Neutral/Alkaline Protease Activity. Mod. Food Sci. Technol. 2020, 157–163. [Google Scholar]
- Afrin, S.; Tamanna, T.; Shahajadi, U.F.; Bhowmik, B.; Jui, A.H.; Miah, M.A.S.; Bhuiyan, M.N.I. Characterization of protease-producing bacteria from garden soil and antagonistic activity against pathogenic bacteria. Microbe 2024, 4, 100123. [Google Scholar] [CrossRef]
- Chen, F. Identification, Characterisation and Expression Vector Construction of a Protease-Producing Bacterium. Doctoral Thesis, Henan University of Technology, Zhengzhou, China, 2023. [Google Scholar]
- Huang, X.; Li, H.; Han, T.; Wang, J.; Ma, Z.; Yu, X. Isolation and identification of protease-producing Bacillus amyloliquefaciens LX-6 and its application in the solid fermentation of soybean meal. Front. Bioeng. Biotechnol. 2023, 11, 119–123. [Google Scholar] [CrossRef]
- Luong, H.-Q.; Le, T.-N.; Lee, P.-H.; Hsieh, P.-C. Optimization of nonspecific protease activity fabrication by Bacillus subtilis N30 isolated from Taiwan using different models of response surface methodology. Biocatal. Agric. Biotechnol. 2023, 50, 102686. [Google Scholar] [CrossRef]
- Zhang, A.; Ma, Y.; Deng, Y.; Zhou, Z.; Cao, Y.; Yang, B.; Bai, J.; Sun, Q. Enhancing Protease and Amylase Activities in Bacillus licheniformis XS-4 for Traditional Soy Sauce Fermentation Using ARTP Mutagenesis. Foods 2023, 12, 2381. [Google Scholar] [CrossRef]
- Liu, Y.; Feng, J.; Pan, H.; Zhang, X.; Zhang, Y. Genetically engineered bacterium: Principles, practices, and prospects. Front. Microbiol. 2022, 13, 997587. [Google Scholar] [CrossRef]

| Considerations | Level | |
|---|---|---|
| −1 | 1 | |
| X1, glucose (g/L) | 12 | 14 |
| X2, inoculum (%) | 3 | 5 |
| X3, initial pH | 7 | 8 |
| X4, fermentation temperature (°C) | 35 | 39 |
| X5, NaCl (g/L) | 0.1 | 0.5 |
| X6, phosphate (g/L) | 1.27 | 5 |
| X7, soy meal powder (g/L) | 12 | 16 |
| Considerations | Level | ||
|---|---|---|---|
| −1 | 0 | +1 | |
| A. fermentation temperature (°C) | 35 | 37 | 39 |
| B. initial pH | 7 | 7.5 | 8 |
| C. soy meal starch (g/L) | 12 | 14 | 16 |
| Parameter | Strain NwMCC01910137 |
|---|---|
| pH | 8.5 |
| Glucose fermentation | + |
| Liquefaction of gelatine | + |
| Citrate | + |
| Starch hydrolysis | + |
| Catalase (enzyme) | + |
| Methyl red | + |
| Phenylalanine deaminase (PAD) | − |
| V-P test | + |
| Indole test | − |
| Optimum temperature | 35 °C |
| Hydrogen sulfide generation | − |
| Fructose | + |
| Ornithine decarboxylase (ODX) | − |
| Inositol | − |
| Arginine dihydrolase | − |
| Lysine decarboxylase (LDC) | − |
| D-mannitol | + |
| L-rhamnose | − |
| Aerobicity | Aerobic |
| Serial Number | X1 | X2 | X3 | X4 | X5 | X6 | X7 | Enzyme Activity (U/mL) |
|---|---|---|---|---|---|---|---|---|
| 1 | −1 | −1 | −1 | −1 | −1 | −1 | −1 | 72.80 |
| 2 | 1 | 1 | −1 | 1 | −1 | −1 | −1 | 50.69 |
| 3 | 1 | −1 | 1 | −1 | −1 | −1 | 1 | 88.64 |
| 4 | 1 | 1 | −1 | 1 | 1 | −1 | 1 | 156.62 |
| 5 | 1 | 1 | 1 | −1 | 1 | 1 | −1 | 43.49 |
| 6 | −1 | 1 | 1 | 1 | −1 | 1 | 1 | 159.65 |
| 7 | −1 | 1 | 1 | −1 | 1 | −1 | −1 | 56.17 |
| 8 | 1 | −1 | −1 | −1 | 1 | 1 | 1 | 87.98 |
| 9 | −1 | −1 | 1 | 1 | 1 | −1 | 1 | 138.53 |
| 10 | −1 | 1 | −1 | −1 | −1 | 1 | 1 | 17.75 |
| 11 | −1 | −1 | −1 | 1 | 1 | 1 | −1 | 57.95 |
| 12 | 1 | −1 | 1 | 1 | −1 | 1 | −1 | 140.32 |
| Serial Number | A | B | C | Protease Activity (U/mL) |
|---|---|---|---|---|
| 1 | 1 | 1 | 0 | 145.79 |
| 2 | 1 | 0 | 1 | 128.24 |
| 3 | −1 | 0 | −1 | 82.17 |
| 4 | 0 | 1 | −1 | 92.66 |
| 5 | −1 | 0 | −1 | 116.23 |
| 6 | 1 | −1 | 0 | 104.94 |
| 7 | 0 | 0 | 0 | 164.74 |
| 8 | −1 | 1 | 0 | 145.53 |
| 9 | 0 | −1 | −1 | 68.71 |
| 10 | 0 | 0 | 0 | 159.52 |
| 11 | 0 | 0 | 0 | 154.64 |
| 12 | 0 | 0 | 0 | 162.29 |
| 13 | 0 | 0 | 0 | 166.32 |
| 14 | 0 | −1 | 1 | 100.25 |
| 15 | 0 | 1 | 1 | 146.12 |
| 16 | 1 | −1 | 0 | 135.70 |
| 17 | −1 | 0 | 1 | 126.72 |
| Source of Variance | Square Sum | Degrees of Freedom | Mean Square | F-value | p-Value |
|---|---|---|---|---|---|
| Model | 14,745.23 | 9 | 1638.36 | 48.83 | <0.0001 ** |
| A—fermentation temperature | 554.35 | 1 | 554.35 | 16.52 | 0.0048 * |
| B—initial pH | 1815.51 | 1 | 1815.51 | 54.11 | 0.0002 * |
| C—soy meal powder | 2505.26 | 1 | 2505.26 | 74.67 | <0.0001 ** |
| AB | 232.44 | 1 | 232.44 | 6.93 | 0.0338 * |
| AC | 264.68 | 1 | 264.68 | 7.89 | 0.0262 * |
| BC | 120.03 | 1 | 120.03 | 3.58 | 0.1005 |
| A2 | 308.18 | 1 | 308.18 | 9.19 | 0.0191 * |
| B2 | 1676.93 | 1 | 1676.93 | 49.98 | 0.0002 * |
| C2 | 6605.53 | 1 | 6605.53 | 196.87 | <0.0001 ** |
| Residual | 234.87 | 7 | 33.55 | ||
| Lack of fit | 149.53 | 3 | 49.84 | 2.34 | 0.2151 |
| Total error | 85.33 | 4 | 21.33 | ||
| Total | 14,980.10 | 16 |
| No | Strains | Enzyme Activity (U/mL) | Strain Origin | Reference |
|---|---|---|---|---|
| 1 | B. subtilis | 166.83 | Slaughterhouse sludge | Current experiment |
| 2 | B. subtilis | 152 | Soil | [50] |
| 3 | B. subtilis | 40.39 | Soy fermented products | [48] |
| 4 | B. subtilis | 638.5 | Plateau soil | [49] |
| 5 | B. subtilis (botany) | 50 | Laboratory culture | [51] |
| 6 | B. subtilis | 143.54 | Laboratory culture | [52] |
Disclaimer/Publisher’s Note: The statements, opinions and data contained in all publications are solely those of the individual author(s) and contributor(s) and not of MDPI and/or the editor(s). MDPI and/or the editor(s) disclaim responsibility for any injury to people or property resulting from any ideas, methods, instructions or products referred to in the content. |
© 2024 by the authors. Licensee MDPI, Basel, Switzerland. This article is an open access article distributed under the terms and conditions of the Creative Commons Attribution (CC BY) license (https://creativecommons.org/licenses/by/4.0/).
Share and Cite
Ma, X.; Li, Y.; Abdul, P.M.; Ding, G.; Indera Luthfi, A.A.; Ismail, A.; Kurniawan, S.B. Screening, Identification, and Optimization of Enzyme Production for Bacteria with High Efficiency of Bovine Blood Protein Degradation from Slaughterhouses. Water 2024, 16, 3508. https://doi.org/10.3390/w16233508
Ma X, Li Y, Abdul PM, Ding G, Indera Luthfi AA, Ismail A, Kurniawan SB. Screening, Identification, and Optimization of Enzyme Production for Bacteria with High Efficiency of Bovine Blood Protein Degradation from Slaughterhouses. Water. 2024; 16(23):3508. https://doi.org/10.3390/w16233508
Chicago/Turabian StyleMa, Xianying, Yantong Li, Peer Mohamed Abdul, Gongtao Ding, Abdullah Amru Indera Luthfi, Abbas Ismail, and Setyo Budi Kurniawan. 2024. "Screening, Identification, and Optimization of Enzyme Production for Bacteria with High Efficiency of Bovine Blood Protein Degradation from Slaughterhouses" Water 16, no. 23: 3508. https://doi.org/10.3390/w16233508
APA StyleMa, X., Li, Y., Abdul, P. M., Ding, G., Indera Luthfi, A. A., Ismail, A., & Kurniawan, S. B. (2024). Screening, Identification, and Optimization of Enzyme Production for Bacteria with High Efficiency of Bovine Blood Protein Degradation from Slaughterhouses. Water, 16(23), 3508. https://doi.org/10.3390/w16233508







